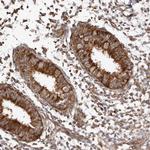
WEE2 Antibody in Immunohistochemistry (Paraffin) (IHC (P))

Search
Invitrogen
WEE2 Polyclonal Antibody
{{$productOrderCtrl.translations['antibody.pdp.commerceCard.promotion.promotions']}}
{{$productOrderCtrl.translations['antibody.pdp.commerceCard.promotion.viewpromo']}}
{{$productOrderCtrl.translations['antibody.pdp.commerceCard.promotion.promocode']}}: {{promo.promoCode}} {{promo.promoTitle}} {{promo.promoDescription}}. {{$productOrderCtrl.translations['antibody.pdp.commerceCard.promotion.learnmore']}}
产品信息
PA5-55606
种属反应
宿主/亚型
分类
类型
抗原
偶联物
形式
浓度
规格
纯化类型
保存液
内含物
保存条件
运输条件
RRID
产品详细信息
Immunogen sequence: TKSGNHFEEP KLKDILLQIS LGLNYIHNSS MVHLDIKPSN IFICHKMQSE SSGVIEEVEN EADWFLSANV MYKIGDLGHA TSINKPKVEE GD
Highest antigen sequence identity to the following orthologs: Mouse - 83%, Rat - 82%.
靶标信息
Oocyte-specific protein tyrosine kinase that phosphorylates and inhibits CDK1/CDC2 and acts as a key regulator of meiosis during both prophase I and metaphase II (PubMed:29606300). Required to maintain meiotic arrest in oocytes during the germinal vesicle (GV) stage, a long period of quiescence at dictyate prophase I, by phosphorylating CDK1 at 'Tyr-15', leading to inhibit CDK1 activity and prevent meiotic reentry. Also required for metaphase II exit during egg activation by phosphorylating CDK1 at 'Tyr-15', to ensure exit from meiosis in oocytes and promote pronuclear formation. [UniProt]
仅用于科研。不用于诊断过程。未经明确授权不得转售。
篇参考文献 (0)
生物信息学
蛋白别名: WEE1 homolog 2; Wee1-like protein kinase 1B; Wee1-like protein kinase 2; Wee1B kinase
基因别名: OOMD5; OZEMA5; WEE1B; WEE2
UniProt ID: (Human) P0C1S8
Entrez Gene ID: (Human) 494551